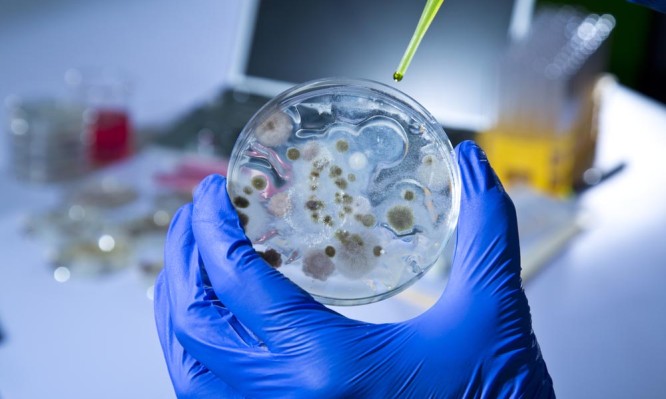

Ολοένα και πιο ανθεκτικά τα βακτήρια στα αντιβιοτικά – Τι λύση προκρίνουν οι επιστήμονες
Έτσι, άρχισε να καταβάλλεται προσπάθεια προκειμένου να χρησιμοποιηθούν ως σύμμαχοι των γιατρών, σε ρόλο ζωντανών αντιβιοτικών, άλλα μικρόβια που θα ξεφορτωθούν τα ανθεκτικά βακτήρια. Επιστήμονες στη Βρετανία χρησιμοποίησαν επιθετικά βακτήρια για να εξοντώσουν παθογόνους μικροοργιανισμούς και έτσι να «καθαρίσουν» λοιμώξεις σε πειραματόζωα.
Το βακτηριοφάγο βακτήριο Bdellovibrio bacteriovorus χρησιμοποιήθηκε με επιτυχία εναντίον βακτηρίων «Σιγκέλλα», που προκαλούν τροφικές δηλητηριάσεις σε περίπου 160 εκατομμύρια ανθρώπους κάθε χρόνο, από τους οποίους πάνω από ένα εκατομμύριο πεθαίνουν.
Οι ερευνητές των πανεπιστημίων Imperial College του Λονδίνου και Νότιγχαμ, που έκαναν τη σχετική δημοσίευση στο περιοδικό βιολογίας «Current Biology», έδειξαν σε πρώτη φάση, σε κυτταρικές καλλιέργειες στο εργαστήριο, ότι οι βακτηριοφάγοι οδήγησαν σε δραστική μείωση κατά 4.000 φορές του πληθυσμού του υπερ-μικροβίου «Σιγκέλλα».
Περαιτέρω τεστ σε ψάρια, που είχαν «μολυνθεί» και με το Bdellovibrio bacteriovorus εκτός από «Σιγκέλλα», έδειξαν ότι το 60% επιβίωσαν, έναντι ποσοστού επιβίωσης μόνο 25% σε εκείνα τα ψάρια όπου δεν είχε εισαχθεί ο βακτηριοφάγος.
Οι πρώτες δοκιμές της τακτικής «βακτήρια εναντίον βακτηρίων» δεν δείχνουν κάποιες ανησυχητικές παρενέργειες. Αν και η όλη ιδέα είναι ασυνήθιστη, αναμένεται να εξετασθεί περαιτέρω ως μια εναλλακτική λύση κατά των ανθεκτικών μικροβίων.
Για «σημαντικό ορόσημο στη χρήση ενός ζωντανού αντιβιοτικού, που θα μπορούσε να χρησιμοποιηθεί σε ζώα και σε ανθρώπους», έκανε λόγο ο επικεφαλής ερευνητής δρ Σερτζ Μοστόβι του Imperial, σύμφωνα με το BBC.
Οι επιστήμονες τόνισαν ότι ασφαλώς θα χρειασθούν πολλές περισσότερες δοκιμές ασφαλείας, προτού επιδιωχθεί η χρήση ζωντανών αντιβιοτικών για θεραπευτικούς σκοπούς σε ασθενείς.
Το ίδιο βακτήριο Bdellovibrio bacteriovorus, το οποίο έχει βρεθεί να ζει φυσικά στο ανθρώπινο σώμα χωρίς να προκαλεί πρόβλημα, έχει διαπιστωθεί ότι μπορεί να σκοτώσει διάφορα άλλα βακτήρια, όπως τα κολοβακτηρίδια και τη σαλμονέλα.
Από το ΑΠΕ-ΜΠΕ







